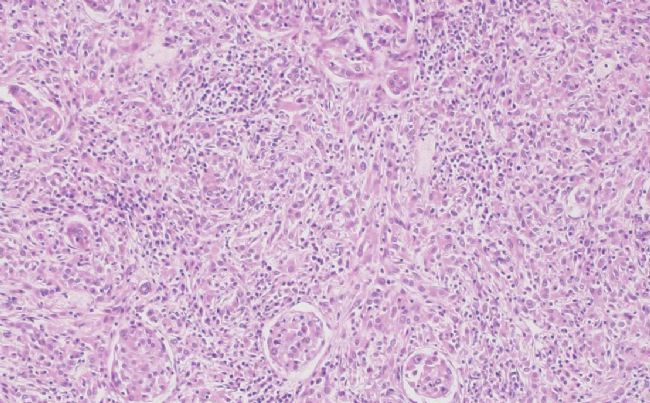
奧林巴斯CX33顯微鏡的使用方法

奧林巴斯CX33顯微鏡的使用方法
全新的生物顯微鏡奧林巴斯OlympusCX33體現(xiàn)人性化的設(shè)計(jì)理念,將操作與使用精簡化,不但提高了使用時(shí)的舒適感,還提高了工作效率。這臺(tái)顯微鏡將人的使用習(xí)慣與顯微鏡機(jī)身框架完美結(jié)合,滿足人體工學(xué)的使用要求,使操作簡單、舒適、高效。

正如OlympusCX33的設(shè)計(jì)理念所體現(xiàn)的一般,奧林巴斯Olympus顯微鏡CX33使用方法十分簡單,基本均可實(shí)現(xiàn)單手操作,正可謂是“抬手安裝,立即使用”。
在我們得到該顯微鏡的時(shí)候,首先就是將其進(jìn)行實(shí)驗(yàn)檢驗(yàn)。那么奧林巴斯CX33的使用方法是什么呢?Olympus顯微鏡CX33使用方法就是指其怎么使用,其實(shí)非常簡單,我們主要來看看這臺(tái)顯微鏡在使用時(shí)的具體優(yōu)勢。
使用步驟:
第一步我們要將顯微鏡放在舒適的觀察環(huán)境下(平整的桌面或?qū)嶒?yàn)臺(tái)上),然后對(duì)顯微鏡進(jìn)行微調(diào),即對(duì)光、調(diào)焦等。

接著,將我們要觀察的樣品放在載物臺(tái)的載玻片上。這時(shí),奧林巴斯CX33的優(yōu)勢就體現(xiàn)出來了,對(duì)樣品的放置我們可以用單手快速地將樣品放入取出。樣品夾夾口略開,在操作過程中將樣品牢牢夾住。這種多用樣品夾適用于多種樣品類型,這其中包括血球計(jì)。

接下來,我們就可以進(jìn)行重要的一步,即對(duì)觀察進(jìn)行調(diào)節(jié),使樣品能夠清晰地展現(xiàn)在我們的視野內(nèi),具體可以調(diào)節(jié)載物臺(tái)的X/Y向,以及W/D,該顯微鏡的載物臺(tái)是機(jī)械固定載物臺(tái)(W×D): 211 mm×154 mm ,行程(X×Y): 76 mm×52 mm ,最大程度的調(diào)節(jié)觀察的清晰度。
奧林巴斯Olympus顯微鏡CX33高效的調(diào)焦旋鈕可以使操作者在使用顯微鏡觀察的同時(shí),能夠?qū)㈦p手及前臂放在觀察臺(tái)上,有助于實(shí)現(xiàn)肢體的舒適度提升。聚焦塞可以在高放大倍數(shù)觀察時(shí),防止樣品意外碰撞物鏡。
當(dāng)一切準(zhǔn)備就緒時(shí),我們就可以通過目鏡的觀察來對(duì)樣品的圖像進(jìn)行捕捉。[目鏡10X 視場直徑 (FN): 20 ;15X 視場直徑 (FN): 16 可選]
當(dāng)需要使用不同的倍數(shù)時(shí),我們可以通過變換擁有4孔位的物鏡轉(zhuǎn)盤來變換觀察的物鏡鏡倍數(shù),該顯微鏡的物鏡具有平場消色差的功能,倍數(shù)也可實(shí)現(xiàn)10、40、100等的變化。

對(duì)于奧林巴斯Olympus顯微鏡CX33的使用方法我們可以在具體的實(shí)驗(yàn)中進(jìn)行體驗(yàn),畢竟是新產(chǎn)品,很難有較為直觀的使用方法步驟,因此我們只能對(duì)其在使用時(shí)的最大優(yōu)勢進(jìn)行描述。在使用過程中對(duì)于要求相對(duì)較低僅使用明視野和暗視野的場合,CX33顯微鏡是一個(gè)理想的選擇。低位配置的物鏡轉(zhuǎn)換器、載物臺(tái)、聚焦鎖、樣品夾和內(nèi)置的換鏡旋座使其能通過簡單配置即可很好地應(yīng)用于日常觀察。

其雙人共覽附件/ U-DO3也是該產(chǎn)品的一大亮點(diǎn),可以允許兩位操作者,在相同的放大倍數(shù)、亮度條件下,從同一方向?qū)我粯悠愤M(jìn)行雙重、同步觀察。同時(shí)也可以使用指針指示樣品的特定部位,以此在簡化培訓(xùn)過程的同時(shí)強(qiáng)化研究探討。

奧林巴斯CX33生物顯微鏡在做常規(guī)實(shí)驗(yàn)時(shí),實(shí)驗(yàn)操作者會(huì)倍感舒適。因?yàn)檫@臺(tái)將人手與控制旋鈕進(jìn)行很好匹配的顯微鏡鏡架,最大程度地符合了人體工學(xué)的要求,提高了工作效率。此外,操作者在使用一只手調(diào)節(jié)焦距和載物臺(tái)的時(shí)候,另一只手可以迅速地放置樣品,從而使得操作動(dòng)作最少化。同時(shí),這種型號(hào)的顯微鏡帶有用于數(shù)字成像的攝像端口,對(duì)于實(shí)驗(yàn)過程中的圖像捕捉分析起到至關(guān)重要的作用。
奧林巴斯CX33生物顯微鏡的使用方法其實(shí)和很多顯微鏡一樣,總體來講就是調(diào)節(jié)光源以及鏡頭之間的焦距,邊調(diào)節(jié)邊進(jìn)行觀察,直到觀察到的圖像清晰為止。如果為顯微鏡連接顯微鏡相機(jī)之后,那么使用的方法就會(huì)較為簡單,具體細(xì)節(jié)可致電咨詢我們。

我們?cè)谑褂脢W林巴斯CX33生物顯微鏡的過程中,要時(shí)刻注意樣品與物鏡的距離,以免直接接觸對(duì)樣品以及物鏡造成破壞,從而影響觀察效果。
更加詳細(xì)的使用步驟用戶可以直接咨詢北京瑞科中儀技術(shù)服務(wù)人員。